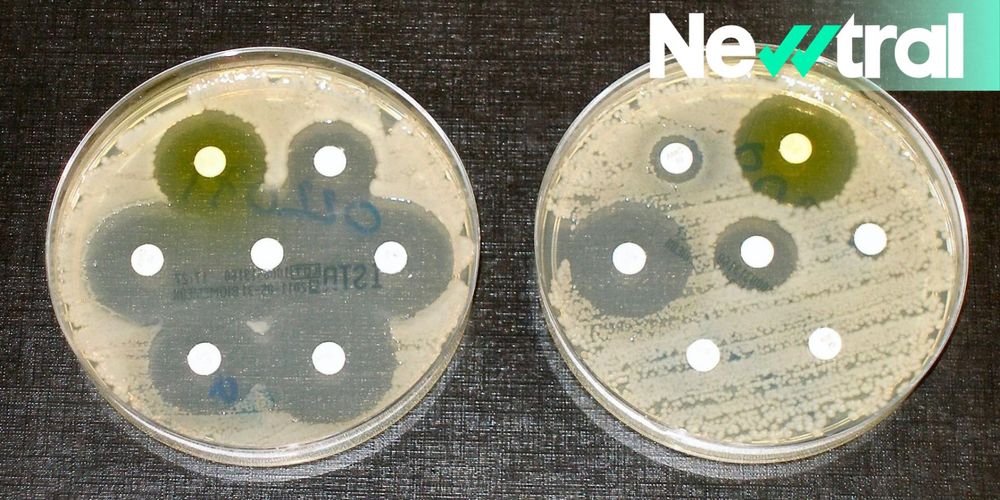

Hoy preguntamos al investigador de nuestra red, Marc Torrent (@uab.cat).👇
🔗 https://tinyurl.com/b6bhwupy
Hoy preguntamos al investigador de nuestra red, Marc Torrent (@uab.cat).👇
🔗 https://tinyurl.com/b6bhwupy
🔎 La OMS ha presentado a cuatro particularmente preocupantes, porque nos estamos quedando sin antibióticos que funcionen contra ellas.

🔎 La OMS ha presentado a cuatro particularmente preocupantes, porque nos estamos quedando sin antibióticos que funcionen contra ellas.
#promocióndelasalud

#promocióndelasalud
esrt.site/actualidad/5...

esrt.site/actualidad/5...
Te contamos más 👇

Te contamos más 👇
✍️ Gemma del Caño.

✍️ Gemma del Caño.
🔎 Un equipo español ha estudiado esto.
🔎 Un equipo español ha estudiado esto.
‼️ "Si no actuamos ya, nos abocamos a una era donde una simple infección vuelva a ser mortal"
tinyurl.com/4p59wpdb

‼️ "Si no actuamos ya, nos abocamos a una era donde una simple infección vuelva a ser mortal"
tinyurl.com/4p59wpdb
¿A qué esperáis para verlo?
🎙️: www.youtube.com/watch?v=BWQ_...

¿A qué esperáis para verlo?
🎙️: www.youtube.com/watch?v=BWQ_...
Laura Espina 👩🏻🔬, ARAID en @ia2-uz-cita.bsky.social ofreció la charla🦠“Superbacterias en la comida”, sobre el reto de la resistencia antimicrobiana
🔗 unizar.es/actualidad/v...



Laura Espina 👩🏻🔬, ARAID en @ia2-uz-cita.bsky.social ofreció la charla🦠“Superbacterias en la comida”, sobre el reto de la resistencia antimicrobiana
🔗 unizar.es/actualidad/v...
👋 La respuesta con Clarissa Wrights en el siguiente reporte ⤵️

👋 La respuesta con Clarissa Wrights en el siguiente reporte ⤵️
❌ La marca ha retirado 300.000 botellas y ha bloqueado la distribución de cientos de miles más
lrzn.es/rf3nd2

❌ La marca ha retirado 300.000 botellas y ha bloqueado la distribución de cientos de miles más
lrzn.es/rf3nd2
La inteligencia artificial resuelve en dos días un problema que tomó años a los científicos La inteligencia artificial está revolucionando la ciencia a un ritmo vertiginoso. En un descubrimiento sin…

La inteligencia artificial resuelve en dos días un problema que tomó años a los científicos La inteligencia artificial está revolucionando la ciencia a un ritmo vertiginoso. En un descubrimiento sin…

Este avance puede ser clave en la lucha contra las #superbacterias 🦠
🔗 upo.es/diario/cienc...

Este avance puede ser clave en la lucha contra las #superbacterias 🦠
🔗 upo.es/diario/cienc...

